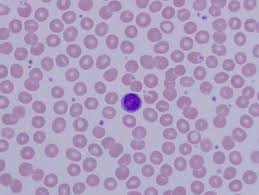
<p>Appearance: Large spherical nucleus, no visible granules</p><p>Function: Direct cell attack via antibodies</p>
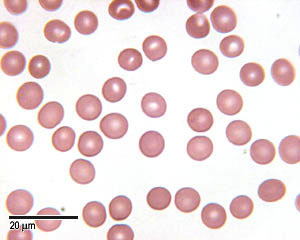
<p>Appearance: Bi concave, thin center, thick edges, light pink</p><p>Function: Transport O2 and CO2</p>

[BIO139] Blood Cell Histology
1/17
Earn XP
Description and Tags
Basic cell histology of formed elements in the blood
Name | Mastery | Learn | Test | Matching | Spaced | Call with Kai |
|---|
No analytics yet
Send a link to your students to track their progress
18 Terms
Neutrophils
Appearance: Three lobed nucleus, small granules
Function: Phagocytize bacteria

Lymphocytes
Appearance: Large spherical nucleus, no visible granules
Function: Direct cell attack via antibodies
Monocytes
Appearance: “Kidney bean” shaped nucleus, no visible granules
Function: Phagocytosis, develops into macrophages in the tissues

Eosinophils
Appearance: Bi-lobed nucleus, bright red granules
Function: Kill parasitic worm infections

Basophils
Appearance: Bi-lobed nucleus, purple/blue granules
Function: Drives allergic reactions, releases histamine to promote inflammation

Erythrocytes
Appearance: Bi concave, thin center, thick edges, light pink
Function: Transport O2 and CO2
Thrombocytes
Appearance: Purple scattered fragments
Function: Blood clotting

Antigens
Any substance (commonly proteins, polysaccharides, lipids, or nucleic acids) that the immune system recognizes as foreign or harmful, triggering a targeted immune response.
Antibodies
Y-shaped protein produced by the immune system's B cells to identify, neutralize, and destroy foreign substances known as antigens, such as bacteria, viruses, and toxins.
Agglutinogens
An antigen that stimulates the production of an agglutinin. (Inherited, RBC type “markers”)
Agglutinins
An antibody, lectin, or other substance that causes agglutination.
Leukocytosis
WBC count above normal, can indicate disease or inflammation.
Leukopenia
WBC count below normal, can indicate poisoning or infectious disease (Ex: AIDS).
Polycythemia
RBC count above normal, can indicate cancer or high exercise, high altitude, dehydration.
Anemia
Inadequate ability to transport oxygen. Can be the result of decreased RBC count or decreased hemoglobin count. Different types.
Inadequate erythropoiesis
Inadequate ability to transport oxygen due to lack of RBC production.
Hemorrhagic Anemia
Inadequate ability to transport oxygen due to blood loss.
Hemolytic Anemia
Inadequate ability to transport oxygen due to RBC destruction.